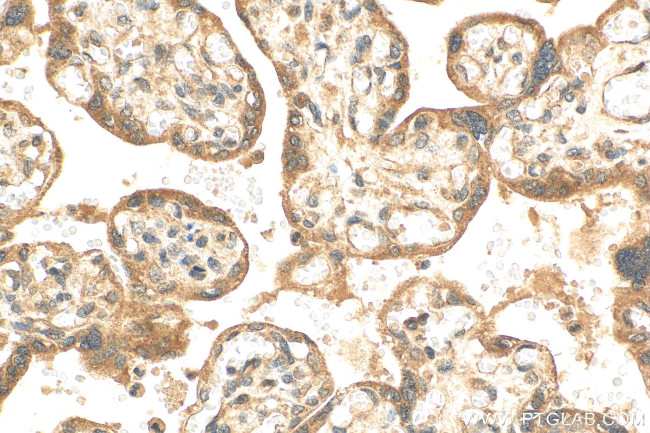
C4orf26 Antibody in Immunohistochemistry (Paraffin) (IHC (P))

Search
Proteintech
C4orf26 Polyclonal Antibody
{{$productOrderCtrl.translations['antibody.pdp.commerceCard.promotion.promotions']}}
{{$productOrderCtrl.translations['antibody.pdp.commerceCard.promotion.viewpromo']}}
{{$productOrderCtrl.translations['antibody.pdp.commerceCard.promotion.promocode']}}: {{promo.promoCode}} {{promo.promoTitle}} {{promo.promoDescription}}. {{$productOrderCtrl.translations['antibody.pdp.commerceCard.promotion.learnmore']}}
产品信息
30132-1-AP
种属反应
宿主/亚型
分类
类型
抗原
偶联物
形式
浓度
规格
纯化类型
保存液
内含物
保存条件
运输条件
产品详细信息
Immunogen sequence: QEEVFTPPGD SQNNADATDC QIFTLTPPPA PRSPVTRAQP ITKTPRCPFH FFPRRPRIHF RFPNRPFVPS RCNHRFPFQP FYWPHRYLTY RYFPRRRLQR GSSSEES
靶标信息
Dental enamel forms the outer cap of teeth and is the hardest substance found in vertebrates. This gene is thought to encode an extracellular matrix acidic phosphoprotein that has a function in enamel mineralization during amelogenesis. Mutations in this gene are associated with recessive hypomineralized amelogenesis imperfecta.
仅用于科研。不用于诊断过程。未经明确授权不得转售。
篇参考文献 (0)
生物信息学
蛋白别名: amelogenesis imperfecta type IIA4; Odontogenesis associated phosphoprotein; uncharacterized protein C4orf26; unnamed protein product
基因别名: AI2A4; C4orf26; ODAPH
UniProt ID: (Human) Q17RF5
Entrez Gene ID: (Human) 152816